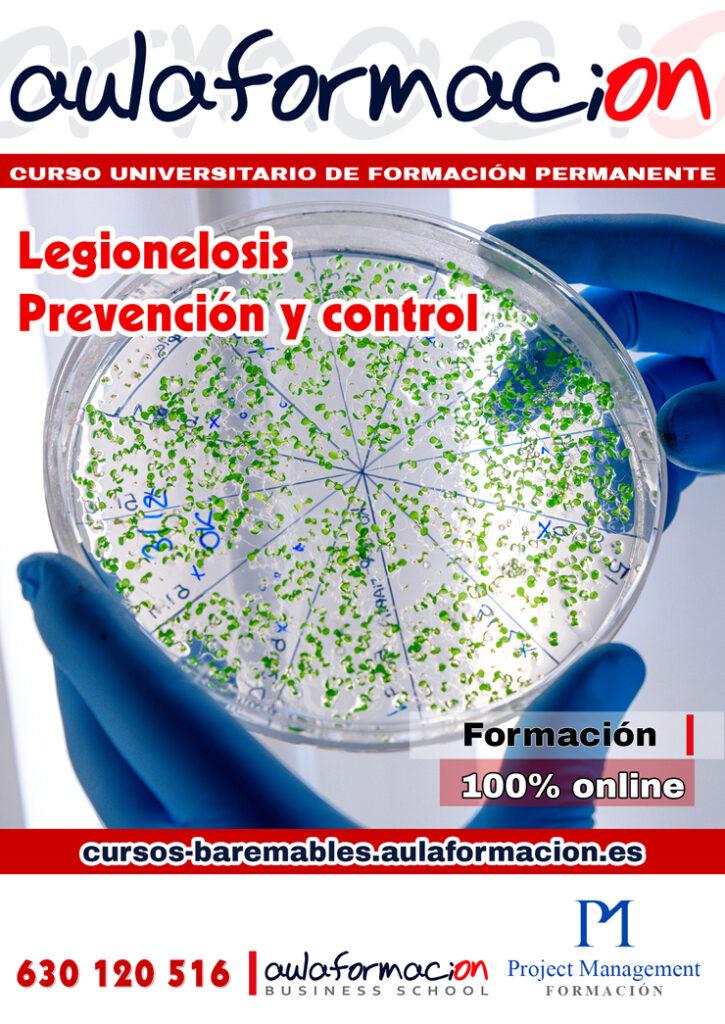
curso-universitario-especializacion-legionelosis-prevencion-control

El derecho sanitario y la legislación sanitaria suelen ser incluidos en el temario de las oposiciones relacionadas con la salud, como por ejemplo:
- Médicos y Enfermeros de Servicios de Salud (Atención Primaria y Especializada)
- Inspectores Sanitarios
- Técnicos Superiores Sanitarios
- Farmacéuticos de la Administración de Sanidad
- Trabajadores Sociales Sanitarios
Además, suelen formar parte del temario de oposiciones específicas de derecho, como por ejemplo las oposiciones a Abogados del Estado o a Cuerpos Jurídicos del Estado, cuando estás son especializadas en derecho sanitario.
¿Qué es el Derecho Sanitario?
El derecho sanitario es una rama transversal emergente del derecho, fundamentalmente derecho público, que regula las relaciones jurídicas que tienen por objeto la salud humana individual y colectiva y su protección.
El derecho sanitario comprende una extensa materia legislativa, que parte desde la confirmación del fundamental derecho a la salud, hasta la regulación del sistema nacional de salud y sus componentes.
El derecho sanitario toca otros campos estrechamente ligados con la salud y el derecho, como el derecho médico, el derecho de la investigación médica, el derecho farmacéutico, el derecho internacional en la sanidad, el derecho de la responsabilidad civil, penal y patrimonial en la práctica sanitaria, el derecho de la biomedicina y el bioderecho.
¿Para qué especializarte en Derecho sanitario?
Un curso de derecho sanitario de puede servir para:
-Comprender el derecho internacional en la sanidad y los modelos de relación entre el paciente y el personal sanitario.
-Conocer los principios de la responsabilidad civil, penal y patrimonial en la práctica sanitaria.
-Analizar el alcance de la asistencia sanitaria, su responsabilidad jurídica, la legislación actual sobre la venta de medicamentos o qué leyes se aplican dentro de la biomedicina.
-Trabajar en despachos de abogados con especialización en derecho sanitario, así como en mutuas de accidentes de trabajo y enfermedades profesionales, compañías de seguros de salud y de responsabilidad civil, departamentos jurídicos en Administraciones públicas con competencias en materia de Sanidad, empresas privadas dedicadas al sector sanitario, laboratorios, compañías farmacéuticas o centros de investigación biomédica y de farmacología aplicada, o entidades sin ánimo de lucro (ONGs) relacionadas con el ámbito sanitario.
Curso universitario en Derecho sanitario
AULAFORMACION te ofrece un curso universitario de especialización en Derecho sanitario de 300 horas, acreditados por la Universidad Europea Miguel de Cervantes (UEMC), por lo que obtendrás un titulo propio o de formación permanente de esta universidad oficial española.
Con la acreditación de un título de diploma de especialización de un curso de derecho sanitario de 300 horas puede ser útil para:
-Demostrar la competencia profesional en el ámbito del derecho sanitario y la biomedicina.
-Obtener un reconocimiento académico de los conocimientos adquiridos en el curso por parte de una universidad.
-Mejorar las oportunidades laborales en el sector sanitario, jurídico o investigado
El derecho sanitario puede incluirse en el temario de varias oposiciones relacionadas con el ámbito de la sanidad, tanto a nivel estatal como autonómico. Algunas de estas oposiciones son:
-Oposiciones a los servicios de salud de cada comunidad autónoma, que engloban diferentes categorías profesionales como médicos, enfermeros, farmacéuticos, técnicos sanitarios, celadores, auxiliares administrativos, etc.
-Oposiciones al Ministerio de Sanidad, que incluyen plazas para personal funcionario y laboral en diferentes áreas como inspección sanitaria, epidemiología, salud pública, gestión sanitaria, etc.
-Oposiciones a otros organismos públicos relacionados con la sanidad, como el Instituto Nacional de Gestión Sanitaria (INGESA), el Instituto de Salud Carlos III (ISCIII), la Agencia Española de Medicamentos y Productos Sanitarios (AEMPS), el Consejo General del Poder Judicial (CGPJ), etc.
El derecho sanitario puede formar parte del temario de estas oposiciones en diferentes bloques o temas, según el nivel y la especialidad de cada convocatoria. Por ejemplo, en las oposiciones al Cuerpo Superior Facultativo de Instituciones Sanitarias de la Junta de Andalucía, especialidad Farmacia, el derecho sanitario se aborda en el bloque II: Legislación Sanitaria General.
Asi disponemos de un pack formativo de 3 cursos universitarios sobre Derecho sanitario para Farmacia.